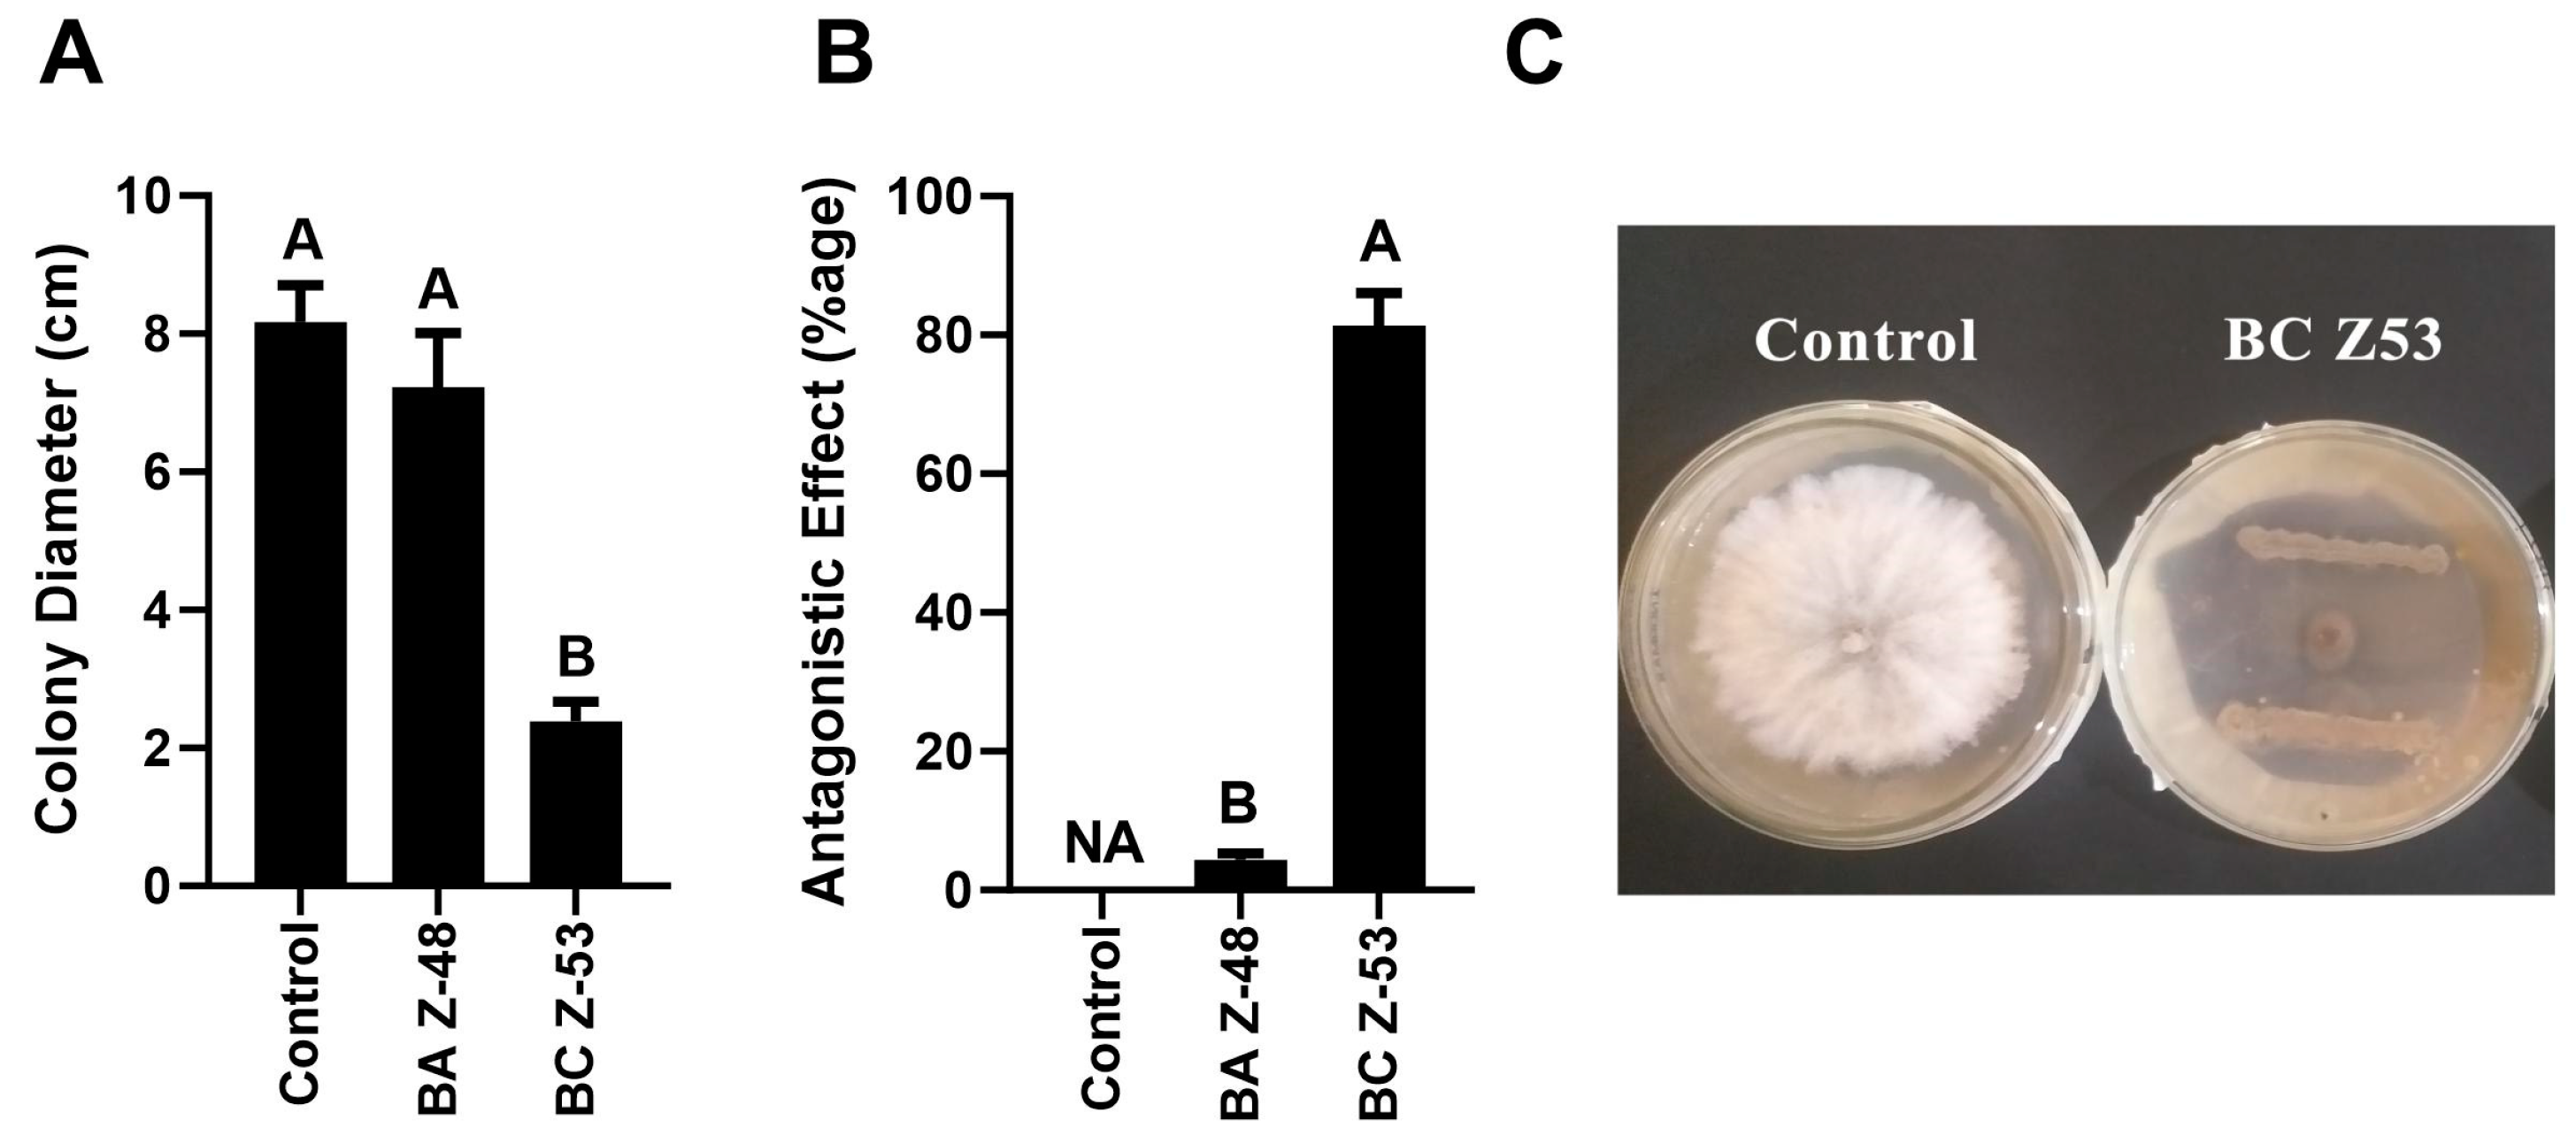
Microorganisms 12 00792 g001

Comparative Effect of Seed Coating and Biopriming of Bacillus aryabhattai Z-48 on Seedling Growth, Growth Promotion, and Suppression of Fusarium Wilt Disease of Tomato Plants
Abstract
1. Introduction
2. Materials and Methods
2.1. Tomato Seeds and Bacterial Microbes
2.2. Analysis of Antagonism against F. oxysporum
2.3. Preparation of Treatments
2.3.1. Biopriming of Tomato Seeds
2.3.2. Coating of Tomato Seeds with Bacterial Strains
2.4. Effect of Seed Coating and Biopriming on Seed Germination and Plant Growth
2.5. Effect of Seed Coating and Biopriming on the Suppression of Fusarium Wilt Disease
2.5.1. Pot Trial
2.5.2. Data Recorded
2.5.3. Exploration of Mechanisms behind Disease Suppression
Quantification of Total Phenolics and Plant Defense-Related Enzymes
Non-Targeted Metabolome Analysis
2.6. Statistical Analysis
3. Results
3.1. Screening of Antagonistic Bacteria
3.2. Effect of Seed Coating and Biopriming of B. aryabhattai Z-48 on Seedling Growth of Tomato
3.3. Effect of Seed Coating and Biopriming of B. aryabhattai Z-48 on the Growth of Tomato Plants
3.4. Effect of Seed Coating and Biopriming of B. aryabhattai Z-48 on Fusarium Wilt Disease Development and Growth of Tomato Plants
3.5. Exploration of Mechanisms behind Disease Suppression
3.5.1. Effect of Seed Coating on Total Phenolic Compounds and Defense-Related Enzymes
3.5.2. Non-Targeted Metabolome Analysis
4. Discussion
5. Conclusions
Supplementary Materials
Author Contributions
Funding
Data Availability Statement
Conflicts of Interest
References
- abu Haraira, A.; Ahmad, A.; Khalid, M.N.; Tariq, M.; Nazir, S.; Habib, I. Enhancing health benefits of tomato by increasing its antioxidant contents through different techniques: A review. Adv. Life Sci. 2022, 9, 131–142. [Google Scholar]
- Ali, M.Y.; Sina, A.A.I.; Khandker, S.S.; Neesa, L.; Tanvir, E.; Kabir, A.; Khalil, M.I.; Gan, S.H. Nutritional composition and bioactive compounds in tomatoes and their impact on human health and disease: A review. Foods 2020, 10, 45. [Google Scholar] [CrossRef]
- Panth, M.; Hassler, S.C.; Baysal-Gurel, F. Methods for management of soilborne diseases in crop production. Agriculture 2020, 10, 16. [Google Scholar] [CrossRef]
- Leite, G.L.D.; Fialho, A. Protection of tomatoes using bagging technology and its role in IPM of Arthropod pests. In Sustainable Management of Arthropod Pests of Tomato; Elsevier: Amsterdam, The Netherlands, 2018; pp. 305–311. [Google Scholar]
- Srinivas, C.; Devi, D.N.; Murthy, K.N.; Mohan, C.D.; Lakshmeesha, T.; Singh, B.; Kalagatur, N.K.; Niranjana, S.; Hashem, A.; Alqarawi, A.A. Fusarium oxysporum f. sp. lycopersici causal agent of vascular wilt disease of tomato: Biology to diversity—A review. Saudi J. Biol. Sci. 2019, 26, 1315–1324. [Google Scholar] [CrossRef]
- Flint, M.L.; van den Bosch, R.; Flint, M.L.; van den Bosch, R. Practical Procedures: IPM Monitoring, Decision-Making, and the Tools and Techniques of the Integrated Pest Manager. In Introduction to Integrated Pest Management; Plenum Press: New York, NY, USA, 1981; pp. 121–179. [Google Scholar]
- Berg, G.; Rybakova, D.; Fischer, D.; Cernava, T.; Vergès, M.-C.C.; Charles, T.; Chen, X.; Cocolin, L.; Eversole, K.; Corral, G.H. Microbiome definition re-visited: Old concepts and new challenges. Microbiome 2020, 8, 103. [Google Scholar]
- Yin, C.; Casa Vargas, J.M.; Schlatter, D.C.; Hagerty, C.H.; Hulbert, S.H.; Paulitz, T.C. Rhizosphere community selection reveals bacteria associated with reduced root disease. Microbiome 2021, 9, 86. [Google Scholar] [CrossRef]
- Heydari, A.; Pessarakli, M. A review on biological control of fungal plant pathogens using microbial antagonists. J. Biol. Sci. 2010, 10, 273–290. [Google Scholar] [CrossRef]
- Khan, A.R.; Mustafa, A.; Hyder, S.; Valipour, M.; Rizvi, Z.F.; Gondal, A.S.; Yousuf, Z.; Iqbal, R.; Daraz, U. Bacillus spp. as bioagents: Uses and application for sustainable agriculture. Biology 2022, 11, 1763. [Google Scholar] [CrossRef]
- Anckaert, A.; Arguelles Arias, A.; Hoff, G.; Calonne-Salmon, M.; Declerck, S.; Ongena, M. The use of Bacillus spp. as bacterial biocontrol agents to control plant diseases. In Microbial Bioprotectants for Plant Disease Management; Köhl, J., Ravensberg, W., Eds.; Burleigh Dodds Science Publishing: Cambridge, UK, 2021. [Google Scholar]
- Santoyo, G.; Orozco-Mosqueda, M.d.C.; Govindappa, M. Mechanisms of biocontrol and plant growth-promoting activity in soil bacterial species of Bacillus and Pseudomonas: A review. Biocontrol Sci. Technol. 2012, 22, 855–872. [Google Scholar] [CrossRef]
- Arora, N.K.; Khare, E.; Maheshwari, D.K. Plant growth promoting rhizobacteria: Constraints in bioformulation, commercialization, and future strategies. In Plant Growth and Health Promoting Bacteria; Springer: Berlin/Heidelberg, Germany, 2011; pp. 97–116. [Google Scholar]
- Cardarelli, M.; Woo, S.L.; Rouphael, Y.; Colla, G. Seed treatments with microorganisms can have a biostimulant effect by influencing germination and seedling growth of crops. Plants 2022, 11, 259. [Google Scholar] [CrossRef]
- Rocha, I.; Ma, Y.; Souza-Alonso, P.; Vosátka, M.; Freitas, H.; Oliveira, R.S. Seed coating: A tool for delivering beneficial microbes to agricultural crops. Front. Plant Sci. 2019, 10, 485509. [Google Scholar] [CrossRef]
- Sujatha, P.; Madhavi, M.; Pallavi, M.; Bharathi, Y.; Rao, P.J.M.; Rajeswari, B.; Kumar, S.P.; Reddy, A.A. Biological Seed Coating Innovations for Sustainable Healthy Crop Growth in Tomato. In Tomato Cultivation and Consumption-Innovation and Sustainability; IntechOpen: London, UK, 2023. [Google Scholar]
- Silva, A.C.L.; Silva, G.A.; Abib, P.H.N.; Carolino, A.T.; Samuels, R.I. Endophytic colonization of tomato plants by the entomopathogenic fungus Beauveria bassiana for controlling the South American tomato pinworm, Tuta absoluta. CABI Agric. Biosci. 2020, 1, 3. [Google Scholar] [CrossRef]
- Ehteshamul-Haque, S.; Sultana, V.; Ara, J.; Athar, M. Cultivar response against root-infecting fungi and efficacy of Pseudomonas aeruginosa in controlling soybean root rot. Plant Biosyst. 2007, 141, 51–55. [Google Scholar] [CrossRef]
- Chin, J.M.; Lim, Y.Y.; Ting, A.S.Y. Biopolymers for biopriming of Brassica rapa seeds: A study on coating efficacy, bioagent viability and seed germination. J. Saudi Soc. Agric. Sci. 2021, 20, 198–207. [Google Scholar] [CrossRef]
- Islam, A.; Anuar, N.; Yaakob, Z. Effect of genotypes and pre-sowing treatments on seed germination behavior of Jatropha. Asian J. Plant Sci. 2009, 8, 433. [Google Scholar] [CrossRef]
- Arnon, D.I. Copper enzymes in isolated chloroplasts. Polyphenoloxidase in Beta vulgaris. Plant Physiol. 1949, 24, 1. [Google Scholar] [CrossRef]
- Hassan, A.; Akram, W.; Rizwana, H.; Aftab, Z.-e.-H.; Hanif, S.; Anjum, T.; Alwahibi, M.S. The Imperative Use of Bacillus Consortium and Quercetin Contributes to Suppress Fusarium Wilt Disease by Direct Antagonism and Induced Resistance. Microorganisms 2023, 11, 2603. [Google Scholar] [CrossRef]
- Hua, G.K.H.; Timper, P.; Ji, P. Meloidogyne incognita intensifies the severity of Fusarium wilt on watermelon caused by Fusarium oxysporum f. sp. niveum. Can. J. Plant Pathol. 2019, 41, 261–269. [Google Scholar] [CrossRef]
- Cachinero, J.; Hervas, A.; Jiménez-Díaz, R.; Tena, M. Plant defence reactions against fusarium wilt in chickpea induced by incompatible race 0 of Fusarium oxysporum f. sp. ciceris and nonhost isolates of F. oxysporum. Plant Pathol. 2002, 51, 765–776. [Google Scholar] [CrossRef]
- Chen, F.; Wang, M.; Zheng, Y.; Luo, J.; Yang, X.; Wang, X. Quantitative changes of plant defense enzymes and phytohormone in biocontrol of cucumber Fusarium wilt by Bacillus subtilis B579. World J. Microbiol. Biotechnol. 2010, 26, 675–684. [Google Scholar] [CrossRef]
- Mozzetti, C.; Ferraris, L.; Tamietti, G.; Matta, A. Variation in enzyme activities in leaves and cell suspensions as markers of incompatibility in different Phytophthora-pepper interactions. Physiol. Mol. Plant Pathol. 1995, 46, 95–107. [Google Scholar] [CrossRef]
- Krishnan, H.B.; Hwangbo, H.; Cha, G.-S.; Cho, J.-Y. Quantitative changes of plant defense enzymes in biocontrol of pepper (Capsicium annuum L.) late blight by antagonistic Bacillus subtilis HJ927. J. Microbiol. Biotechnol. 2005, 15, 1073–1079. [Google Scholar]
- Kostopoulou, S.; Ntatsi, G.; Arapis, G.; Aliferis, K.A. Assessment of the effects of metribuzin, glyphosate, and their mixtures on the metabolism of the model plant Lemna minor L. applying metabolomics. Chemosphere 2020, 239, 124582. [Google Scholar] [CrossRef]
- Lisec, J.; Schauer, N.; Kopka, J.; Willmitzer, L.; Fernie, A.R. Gas chromatography mass spectrometry–based metabolite profiling in plants. Nat. Protoc. 2006, 1, 387–396. [Google Scholar] [CrossRef]
- Onofri, A.; Pannacci, E. Spreadsheet tools for biometry classes in crop science programmes. Commun. Biometry Crop Sci. 2014, 9, 43–53. [Google Scholar]
- Hashem, A.; Tabassum, B.; Abd_Allah, E.F. Bacillus subtilis: A plant-growth promoting rhizobacterium that also impacts biotic stress. Saudi J. Biol. Sci. 2019, 26, 1291–1297. [Google Scholar] [CrossRef]
- Aktuganov, G.; Galimzyanova, N.; Melent’Ev, A.; Kuz’mina, L.Y. Extracellular hydrolases of strain Bacillus sp. 739 and their involvement in the lysis of micromycete cell walls. Microbiology 2007, 76, 413–420. [Google Scholar] [CrossRef]
- Mellidou, I.; Karamanoli, K. Unlocking PGPR-mediated abiotic stress tolerance what lies beneath. Front. Sustain. Food Syst. 2022, 6, 832896. [Google Scholar] [CrossRef]
- Tu, L.; He, Y.; Shan, C.; Wu, Z. Preparation of Microencapsulated Bacillus subtilis SL-13 Seed Coating Agents and Their Effects on the Growth of Cotton Seedlings. BioMed Res. Int. 2016, 2016, 3251357. [Google Scholar] [CrossRef]
- Jetiyanon, K.; Wittaya-Areekul, S.; Plianbangchang, P. Film coating of seeds with Bacillus cereus RS87 spores for early plant growth enhancement. Can. J. Microbiol. 2008, 54, 861–867. [Google Scholar] [CrossRef]
- Agake, S.-I.; Artigas Ramirez, M.D.; Kojima, K.; Ookawa, T.; Ohkama-Ohtsu, N.; Yokoyama, T. Seed coating by biofertilizer containing spores of Bacillus pumilus TUAT1 strain enhanced initial growth of Oryza sativa L. Agron. J. 2021, 113, 3708–3717. [Google Scholar] [CrossRef]
- O’Callaghan, M. Microbial inoculation of seed for improved crop performance: Issues and opportunities. Appl. Microbiol. Biotechnol. 2016, 100, 5729–5746. [Google Scholar] [CrossRef]
- Amara, U.; Khalid, R.; Hayat, R. Soil Bacteria and Phytohormones for Sustainable Crop Production. In Bacterial Metabolites in Sustainable Agroecosystem; Maheshwari, D.K., Ed.; Springer International Publishing: Cham, Switzerland, 2015; pp. 87–103. [Google Scholar]
- Cui, W.; He, P.; Munir, S.; He, P.; Li, X.; Li, Y.; Wu, J.; Wu, Y.; Yang, L.; He, P.; et al. Efficacy of plant growth promoting bacteria Bacillus amyloliquefaciens B9601-Y2 for biocontrol of southern corn leaf blight. Biol. Control 2019, 139, 104080. [Google Scholar] [CrossRef]
- Ndakidemi, P.A.; Dakora, F.D. Legume seed flavonoids and nitrogenous metabolites as signals and protectants in early seedling development. Rev. Funct. Plant Biol. 2003, 30, 729–745. [Google Scholar] [CrossRef]
- Latz, M.A.C.; Jensen, B.; Collinge, D.B.; Jørgensen, H.J.L. Endophytic fungi as biocontrol agents: Elucidating mechanisms in disease suppression. Plant Ecol. Divers. 2018, 11, 555–567. [Google Scholar] [CrossRef]
- Rais, A.; Shakeel, M.; Malik, K.; Hafeez, F.Y.; Yasmin, H.; Mumtaz, S.; Hassan, M.N. Antagonistic Bacillus spp. reduce blast incidence on rice and increase grain yield under field conditions. Microbiol. Res. 2018, 208, 54–62. [Google Scholar] [CrossRef]
- Mhlongo, M.I.; Piater, L.A.; Steenkamp, P.A.; Labuschagne, N.; Dubery, I.A. Metabolic Profiling of PGPR-Treated Tomato Plants Reveal Priming-Related Adaptations of Secondary Metabolites and Aromatic Amino Acids. Metabolites 2020, 10, 210. [Google Scholar] [CrossRef]
- Mashabela, M.D.; Tugizimana, F.; Steenkamp, P.A.; Piater, L.A.; Dubery, I.A.; Terefe, T.; Mhlongo, M.I. Metabolomic evaluation of PGPR defence priming in wheat (Triticum aestivum L.) cultivars infected with Puccinia striiformis f. sp. tritici (stripe rust). Front. Plant Sci. 2023, 14, 1103413. [Google Scholar] [CrossRef]

| Treatments | Shoot Length (cm) | Root Length (cm) | Dry Biomass (g) | Total chl. (mg/g FW) | |
|---|---|---|---|---|---|
| Seed coating | BA Z-48 | 122 ± 11.93 A | 34.57 ± 01.21 A | 93.5 ± 05.47 A | 1.71 ± 0.01 A |
| Process control | 86.9 ± 07.31 C | 28.96 ± 02.17 C | 66.7 ± 03.12 C | 1.23 ± 0.03 C | |
| Biopriming | BA Z-48 | 104 ± 08.06 B | 32.58 ± 01.82 AB | 87.3 ± 06.12 B | 1.64 ± 0.05 AB |
| Process control | 81.7 ± 06.13 CD | 29.42 ± 01.02 C | 61.2 ± 05.12 C | 1.32 ± 0.02 C | |
| Non-treated control | 83.2 ± 08.22 CD | 27.46 ± 01.74 CD | 59.1 ± 07.09 CD | 1.38 ± 0.01 CD | |
| Treatments | Disease Index (%age) | Shoot Length (cm) | Root Length (g) | Dry Biomass (g) | |
|---|---|---|---|---|---|
| Seed coating | BA Z-48 | 23.2 ± 01.86 E | 31.8 ± 02.25 A | 16.7 ± 01.29 A | 8.54 ± 0.65 A |
| Process control | 69.6 ± 05.42 AB | 22.9 ± 01.86 C–E | 07.4 ± 09.16 C–E | 5.92 ± 0.31 CD | |
| Biopriming | BA Z-48 | 35.4 ± 02.27 CD | 28.4 ± 01.46 AB | 14.2 ± 01.47 B | 7.66 ± 0.92 AB |
| Process control | 75.7 ± 04.94 A | 20.0 ± 01.43 DE | 08.6 ± 00.94 CD | 5.34 ± 0.44 CD | |
| Carbendazim control | 41.9 ± 02.67 C | 23.8 ± 00.96 CD | 10.9 ± 07.09 C | 6.94 ± 0.52 BC | |
| Pathogen control | 73.2 ± 04.52 A | 19.3 ± 01.07 EF | 08.31 ± 00.64 CD | 5.31 ± 0.37 CD | |
| Non-treated control | ND | 25.9 ± 00.86 BC | 13.96 ± 01.27 B | 6.18 ± 0.42 BC | |
Disclaimer/Publisher’s Note: The statements, opinions and data contained in all publications are solely those of the individual author(s) and contributor(s) and not of MDPI and/or the editor(s). MDPI and/or the editor(s) disclaim responsibility for any injury to people or property resulting from any ideas, methods, instructions or products referred to in the content. |
© 2024 by the authors. Licensee MDPI, Basel, Switzerland. This article is an open access article distributed under the terms and conditions of the Creative Commons Attribution (CC BY) license (https://creativecommons.org/licenses/by/4.0/).
Share and Cite
Akram, W.; Waqar, S.; Hanif, S.; Anjum, T.; Aftab, Z.-e.-H.; Li, G.; Ali, B.; Rizwana, H.; Hassan, A.; Rehman, A.; et al. Comparative Effect of Seed Coating and Biopriming of Bacillus aryabhattai Z-48 on Seedling Growth, Growth Promotion, and Suppression of Fusarium Wilt Disease of Tomato Plants. Microorganisms 2024, 12, 792. https://doi.org/10.3390/microorganisms12040792
Akram W, Waqar S, Hanif S, Anjum T, Aftab Z-e-H, Li G, Ali B, Rizwana H, Hassan A, Rehman A, et al. Comparative Effect of Seed Coating and Biopriming of Bacillus aryabhattai Z-48 on Seedling Growth, Growth Promotion, and Suppression of Fusarium Wilt Disease of Tomato Plants. Microorganisms. 2024; 12(4):792. https://doi.org/10.3390/microorganisms12040792
Chicago/Turabian StyleAkram, Waheed, Sara Waqar, Sana Hanif, Tehmina Anjum, Zill-e-Huma Aftab, Guihua Li, Basharat Ali, Humaira Rizwana, Ali Hassan, Areeba Rehman, and et al. 2024. "Comparative Effect of Seed Coating and Biopriming of Bacillus aryabhattai Z-48 on Seedling Growth, Growth Promotion, and Suppression of Fusarium Wilt Disease of Tomato Plants" Microorganisms 12, no. 4: 792. https://doi.org/10.3390/microorganisms12040792
APA StyleAkram, W., Waqar, S., Hanif, S., Anjum, T., Aftab, Z.-e.-H., Li, G., Ali, B., Rizwana, H., Hassan, A., Rehman, A., Munir, B., & Umer, M. (2024). Comparative Effect of Seed Coating and Biopriming of Bacillus aryabhattai Z-48 on Seedling Growth, Growth Promotion, and Suppression of Fusarium Wilt Disease of Tomato Plants. Microorganisms, 12(4), 792. https://doi.org/10.3390/microorganisms12040792






